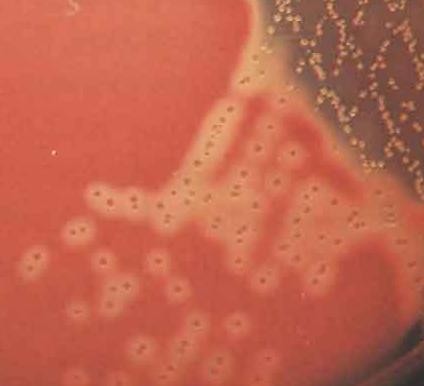
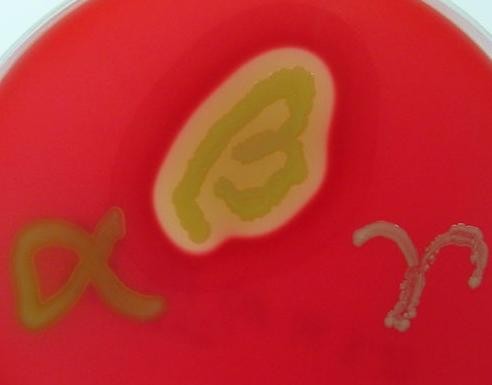
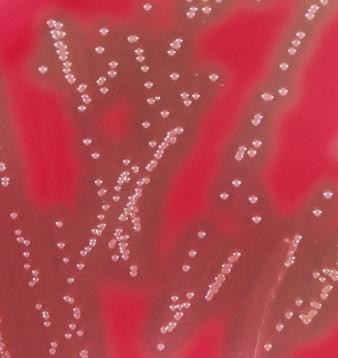

Материал: Литусов_Пиогенные кокки
Стрептококки
Стрептококки – это бактерии сферической формы, располагающиеся цепочками. Стрептококки впервые обнаружил при рожистом воспалении и раневых инфекциях немецкий хирург Т. Биллрот в 1874 г., а при септицемии и гнойных поражениях в 1878 г. французский микробиолог и химик Л. Пастер (рисунок 1.48).


А Б
Рисунок 1.48 – А - Теодор Биллрот (Christian Albert Theodor Billroth, 1829-1894 гг.); Б – Луи Пастер (Louis Pasteur, 1822-1895 гг.). Заимствовано из Интернет-ресурсов.
Немецкий врач Ф. Фелейзен в 1883 г. в лимфатических узлах и подкожной клетчатке обнаружил возбудителя рожистого воспаления.
Таксономическое положение и классификация стрептококков. Название стрептококков происходит от греческих слов streptos – цепочка, kokkos – зерно, ягода. Это название связано с расположением микробных клеток в виде цепочки. Такое расположение обусловлено делением клеток в одной плоскости (рисунок 1.49).


Рисунок 1.49 – Расположение клеток при делении стрептококков.
Стрептококки относятся к типу Firmicutes, классу Bacilli, порядку Lactobacillales, семейству Streptococcaceae, роду Streptococcus. Род Streptococcus включает большое количество видов, среди которых клинически значимыми для человека являются S. pyogenes, S. pneumoniae, S. mutans, S. agalactiae, S. mitis и некоторые другие.
По характеру гемолиза стрептококки подразделяются на 3 группы: альфа- гемолитические, бета-гемолитические и негемолитические или гамма-стрептококки (рисунок 1.50).



 Рисунок
1.50 – Распределение стрептококков по
характеру гемолиза.
Рисунок
1.50 – Распределение стрептококков по
характеру гемолиза.
В 1933 г. американский микробиолог Р. Лэнсфильд (рисунок 1.51) разделила β-гемолитические стрептококки по С-полисахаридному антигену (С-субстанции) на 20 серогрупп (А, В, С, D и т. д.).

Рисунок 1.51 – Ребекка Лэнсфильд (Rebecca Craighill Lancefield, 1895-1981 гг.).
Заимствовано из Интернет-ресурсов.
Например, S. pyogenes относится к серогруппе А, S. agalactiae – к серогруппе В, S. dysgalactiae – к серогруппе С и так далее. Заболевания у людей вызывают чаще всего стрептококки серогрупп А, В и С. Внутри серогрупп она предложила выделять серовары по М-белку (более 100 сероваров).
Глюкоза Мальтоза Сахароза
Рисунок 1.54 – Ферментация углеводов стрептококками.
По характеру роста на кровяном агаре выделяют три группы стрептококков:
-гемолитические стрептококки вызывают образование вокруг колоний зоны зеленоватого цвета, обусловленное превращением гемоглобина в метгемоглобин (условно-патогенные стрептококки, “зеленящие стрептококки” или стрептококки группы “viridans”, например, S. mutans);
-гемолитические стрептококки формируют колонии, окруженные зоной полного гемолиза (рисунок 1.55); к ним относятся патогенные стрептококки, основные возбудители гнойно-воспалительных заболеваний человека, в частности,
S. pyogenes;
Рисунок 1.55 – Гемолиз эритроцитов β-гемолитическими стрептококками.
Заимствовано из Интернет-ресурсов.
- -стрептококки (негемолитические стрептококки) не образуют зоны гемолиза вокруг колоний (например, S. mitis).
Проявление гемолитической активности разных видов стрептококков хорошо иллюстрирует рисунок 1.56.
Рисунок 1.56 – Характер гемолиза у разных видов стрептококков. Заимствовано из Интернет-ресурсов.
Альфа-гемолитические стрептококки широко представлены в ротовой полости, поэтому часто называются оральными стрептококками. Бета- гемолитические стрептококки редко выделяются от здоровых людей, большинство из них являются болезнетворными. Негемолитические стрептококки входят в состав облигатной микробиоты человека.
Антигенная структура стрептококков. Стрептококки имеют групповой полисахаридный С-антиген, в зависимости от особенностей строения которого стрептококки разделены на серогруппы. С-антиген локализуется в клеточной стенке стрептококков. Некоторые виды стрептококков не имеют С-антигена.
В клеточной стенке стрептококков локализуется также белковый М-антиген. Он обладает типовой специфичностью. Структурно М-белок представляет филаменты (пили, фимбрии). По строению М-антигена стрептококки группы А подразделяются на серовары (более 100 сероваров).
Стрептококки имеют так называемые перекрестно реагирующие антигены. Антитела к таким антигенам взаимодействуют (перекрестно реагируют) с тканями миокарда, скелетных мышц, почек.
Резистентность стрептококков. Во внешней среде стрептококки сохраняются в течение нескольких дней. Они выдерживают нагревание до 50-70С в течение 30 минут, хорошо переносят низкие температуры. Стрептококки продолжительное время сохраняются на предметах, окружающих больного, в пыли. В гное, мокроте стрептококки сохраняются месяцами. Чувствительны к дезинфицирующим веществам: например, в 3% феноле они погибают через 15 минут.
Стрептококки чувствительны к пенициллину, устойчивость к пенициллину у них возникает очень редко. К другим же антибиотикам и сульфаниламидам у стрептококков часто развивается резистентность.
Факторы патогенности стрептококков. Основные факторы патогенности стрептококков представлены в таблице 1.4 и на рисунке 1.57. Наличие тех или иных факторов патогенности и их соотношение определяет различную вирулентность разных штаммов стрептококков. Наибольшей патогенностью для человека обладают бета-гемолитические стрептококки серологической группы А.
Таблица 1.4 – Факторы патогенности стрептококков
Факторы |
Роль в развитии инфекции |
1. Структурные компоненты клетки |
|
М-протеин и М-подобные поверхностные протеины (T-, R- белки) |
Предотвращают активацию комплемента по альтернативному пути и препятствуют фагоцитозу; медиаторы адгезии к кератиноцитам кожи |
Капсула |
Защита от фагоцитоза, фактор адгезии и тканевой инвазии |
Фибронектин - связывающие белки (протеины F1, F2, Sfb1, Sfb2, SOF, PFBP, FbaA, FbaB) |
Обеспечивают адгезию, связывают фибронектин, способствуют формированию обширных бактериальных агрегатов и обеспечивают защиту от фагоцитоза в присутствии опсонизирующих антител |
Липотейхоевая кислота (LTA) |
Адгезия к клеткам эпителия |
2. Секретируемые факторы |
|
2.1. Ферменты агрессии |
|
Стрептокиназа (фибринолизин) |
Фибринолитическая активность, распространение |
В настоящее время выделяют около 40 видов стрептококков, которые объединяют в 6 групп (кластеров): Pyogenic, Anginosus, Mitis, Salivarius, Bovis, Mutans.
Морфологические и тинкториальные свойства стрептококков.
Стрептококки представляют собой грамположительные клетки сферической формы
размером 0,5-2,0 мкм. Неподвижные, не образуют спор. Некоторые виды
стрептококков формируют капсулу. Имеют пили (фимбрии). В мазках из агаровых культур стрептококки располагаются короткими цепочками, в препаратах из бульонных культур – длинными цепочками (рисунок 1.52).



а б в
Рисунок 1.52 – Компьютерная визуализация (а), окраска по Граму (б) и электронная фотография (в) стрептококков. Заимствовано из Интернет-ресурсов.
Клеточная стенка стрептококков имеет наружный белковый слой (содержит Т- и М-белки), средний полисахаридный слой (состоит из N-ацетилглюкозамина и L-рамнозы) и внутренний слой (представлен пептидогликаном). Из клеточной стенки через гиалуроновую капсулу выступают фимбрии, содержащие М-белок и липотейхоевую кислоту.
Культуральные и биохимические свойства стрептококков. Стрептококки являются факультативными анаэробами. Хорошо растут в аэробных условиях на питательных средах с кровью, сывороткой крови, асцитической жидкостью, глюкозой. На плотных средах образуют мелкие сероватые колонии. В жидких средах растут в виде небольшого осадка (рисунок 1.53).

а б
Рисунок 1.53 – Характер роста стрептококков на кровяном агаре (а) и в жидкой питательной среде (б). Заимствовано из Интернет-ресурсов.
Стрептококки ферментируют глюкозу, мальтозу, сахарозу и некоторые другие углеводы с образованием кислоты без газа (рисунок 1.54), протеолитическими свойствами не обладают. Каталазоотрицательные.
|
стрептококков в тканях |
Гиалуронидаза |
Фактор инвазии |
Пептидаза |
Способствует распространению бактерий в тканях |
ДНКаза (стрептодорназа) |
Фактор инвазии |
IgG-разрушающий фермент |
Защищает бактерии от опсонизирующих антител, ингибирует фагоцитоз |
2.2. Токсины |
|
Стрептолизины О и S (гемолизины) |
Порообразующие цитотоксины |
Стрептококковые пирогенные экзотоксины (streptococcal pyrogenic exotoxins, SPE) типов А, В и С |
Некротическое действие на эндотелий сосудов |
Лейкоцидин |
Разрушение лейкоцитов |
3. Медиаторы межмикробного взаимодействия |
|
Стрептоцины (бактериоцины) |
Участие в заселении определенных биотопов |
Капсула
 Клеточная
стенка
Клеточная
стенка
Цитоплазматическая мембрана
Токсины
Sfb
М-протеин
F-протеин
LTA
Экзоферменты
Рисунок 1.57 – Факторы патогенности стрептококков.
Белок М (mucoid - слизистый) является одним из основных факторов патогенности стрептококков группы А. По структуре он напоминает пили (ворсинки), определяет адгезивные свойства, угнетает фагоцитоз, адсорбирует на своей поверхности фибриноген и фибрин, маскируя рецепторы для комплемента и опсонинов. Молекула М-белка состоит из двух цепей, образующих спираль. М- белок включает в себя консервативный и гипервариабельный участки. Консервативный участок связывает фибриноген и Fc-фрагменты IgG, формируя псевдокапсулу на поверхности стрептококка. Гипервариабельный участок отвечает за разнообразие эпитопов: известно более 100 вариантов белка, характерных определенному серотипу. Эти варианты отличаются друг от друга последовательностью аминокислот в дистальной (N-концевой) части молекулы (рисунок 1.58).
 Гипервариабельный
участок
Гипервариабельный
участок
М-протеин
Консервативный участок
Пептидогликан
Цитоплазматическая мембрана
Рисунок 1.58 – Структура М-белка S. pyogenes.
Т-белки у большинства стрептококков представлены в виде стабильных комплексов, включающих 2-3 белка. Среди них один белок является основным, а два – вспомогательными. Основной белок определяет Т-тип стрептококка. По Т- белку стрептококки группы А также подразделяются на серовары (несколько десятков).
R-белок обнаруживается у стрептококков серогрупп В, С и D. Он чувствителен к пепсину, разрушается при высокой температуре. Его роль в развитии инфекций окончательно не ясна.
Капсула у стрептококков групп А и С образована гиалуроновой кислотой, а у S. pneumoniae – полисахаридом. Капсула облегчает адгезию микробных клеток к эпителию, препятствует фагоцитозу, экранирует пептидогликан. Гиалуроновая кислота капсулы S. pyogenes аналогична гиалуроновой кислоте млекопитающих, поэтому затрудняет формирование эффективного иммунного ответа на возбудителя инфекции. Кроме собственной капсулы стрептококк способен фиксировать на своей поверхности белки макроорганизма (фибриноген, плазминоген, фибронектин, коллаген и др.), создавая капсулоподобную структуру, защищающую микробную клетку от повреждающих факторов макроорганизма.
Фибронектин-связывающие белки (F1, F2, Sfb1, Sfb2, SOF, PFBP, FbaA, FbaB) способствуют формированию агрегатов и защищают микробные клетки от фагоцитоза. Каждый из этих белков присущ определенному М-типу стрептококка. М-типы, обладающие высокой вирулентностью, могут экспрессировать сразу несколько фибронектин-связывающих белков.
ДНКаза (стрептодорназа) гидролизует ДНК, способствует инвазивности стрептококков, повышает мобильность возбудителя, снижая вязкость экссудата. В клинической практике стрептодорназа используется для разжижения гнойных экссудатов и очищения инфицированных ран.
Стрептокиназа (фибринолизин) представляет собой фермент, способствующий растворению фибриновых сгустков и в результате этого повышающий инвазивные свойства стрептококка. Стрептокиназу используют при лечении легочных эмболий и тромбоза вен (рисунок 1.59).

Рисунок 1.59 – Коммерческий препарат стрептокиназы. Заимствовано из Интернет- ресурсов.
Гиалуронидаза является фактором инвазии, разрушает гиалуроновую кислоту соединительной ткани (межклеточного матрикса) хозяина, способствуя распространению возбудителя по организму.
Пептидаза (С5а-пептидаза) расщепляет С5а-компонент комплемента, препятствует миграции в очаг воспаления нейтрофилов, подавляет подвижность фагоцитов.
Стрептолизин S (stable) – гемолизин, вызывает лизис эритроцитов, обусловливая образование зон гемолиза вокруг колоний на чашках с кровяным агаром. Синтезируется β-гемолитическими стрептококками группы А. Он способен связываться с фосфолипидами и в результате этого повреждать мембраны клеток почек, сердца, легких.
Стрептолизин О (oxygen-sensitive) – белок, относящийся к порообразующим цитотоксинам. Нарушает процессы окислительного фосфорилирования в митохондриях. Антитела к стрептолизину О блокируют гемолиз. Синтезируется β- гемолитическими стрептококками групп А, С и G.
Стрептококковые пирогенные экзотоксины (эритрогенный токсин Дика, токсин сыпи, скарлатинозный токсин, эритрогенин) кодируются генами умеренных бактериофагов или хромосомными генами. У больных скарлатиной эритрогенный токсин вызывает появление ярко-красной сыпи на коже и слизистых оболочках. Скарлатину могут вызывать только те штаммы S. pyogenes, которые продуцируют эритрогенный токсин. Синтез эритрогенного токсина у возбудителя скарлатины связан с лизогенией: токсин синтезируют только те штаммы, которые заражены умеренным бактериофагом. Штаммы, не зараженные умеренным фагом, не продуцируют токсин. Эритрогенный токсин обладает некротическим действием на эндотелий сосудов.
Стрептококковые пирогенные токсины вызывают активацию Т-лимфоцитов и последующий выброс цитокинов, которые оказывают системный токсический эффект на организм (лихорадка, рвота, диарея, сыпь, боли в мышцах, снижение артериального давления).
Лейкоцидин разрушает лейкоциты, подавляет фагоцитоз.
Кардиогепатический токсин продуцируют некоторые штаммы стрептококков группы А. Этот токсин вызывает поражение миокарда и образование гранулем в печени.
Стрептоцины (бактериоцины) стрептококков относятся к группе медиаторов межмикробного взаимодействия. Они участвуют в колонизации стрептококками определенного биотопа организма, препятствуя размножению других бактерий.